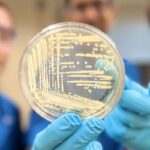
SciTechDaily

La recherche révèle que la mise en œuvre stratégique de technologies de refroidissement à Riyad peut abaisser les températures de 4,5°C et réduire la demande énergétique, offrant ainsi une solution durable pour lutter contre la chaleur urbaine et améliorer la qualité de vie.
L’utilisation d’une combinaison de stratégies et de méthodes de refroidissement a le potentiel de réduire à la fois la température et les besoins énergétiques à Riyad, en Arabie Saoudite.
Une étude récente de l’UNSW Sydney démontre que des réductions significatives des températures dans les grandes villes situées dans des climats désertiques chauds peuvent être obtenues parallèlement à une diminution des dépenses énergétiques.
Les résultats, récemment publiés dans Villes Nature, détaillent une stratégie à multiples facettes pour rafraîchir la capitale de l’Arabie Saoudite jusqu’à 4,5°C, combinant des matériaux de construction « super cool » hautement réfléchissants développés par le laboratoire d’architecture haute performance avec de la verdure irriguée et des mesures de rénovation énergétique. L’étude, menée en collaboration avec la Commission royale de Riyad, est la première à étudier les avantages énergétiques à grande échelle des technologies modernes d’atténuation de la chaleur lorsqu’elles sont mises en œuvre dans une ville.
« Le projet démontre l’impact considérable que les technologies et techniques avancées d’atténuation de la chaleur peuvent avoir pour réduire la surchauffe urbaine, diminuer les besoins de refroidissement et améliorer la vie », déclare Mattheos (Mat) Santamouris, professeur à l’UNSW Scientia, titulaire de la chaire Anita Lawrence en architecture haute performance et auteur principal. de l’étude.
Le professeur Santamouris se spécialise dans le développement de technologies et de stratégies d’atténuation de la chaleur pour réduire les températures urbaines dans les villes. La chaleur urbaine extrême affecte plus de 450 villes dans le monde, augmentant les besoins de consommation d’énergie et ayant un impact négatif sur la santé, notamment sur les maladies et les décès liés à la chaleur.
Riyad, la capitale de l’Arabie Saoudite, est l’une de ces villes. Située au centre d’un désert, c’est l’une des villes les plus chaudes du monde, avec des températures pouvant dépasser les 50°C en été. En outre, le changement climatique et l’urbanisation rapide augmentent l’ampleur de la surchauffe.
« La verdure limitée et les grandes surfaces artificielles faites de matériaux de construction conventionnels comme l’asphalte et le béton emprisonnent la chaleur, ce qui signifie que la ville continue de se réchauffer », explique le professeur Santamouris. « La chaleur supplémentaire due à la pollution automobile et aux activités industrielles augmente également la température de la ville. »
Simulation de scénarios d’atténuation de la chaleur à l’échelle de la ville
Pour l’étude, l’équipe dirigée par des chercheurs de l’UNSW a effectué des simulations climatiques et énergétiques de refroidissement à grande échelle du quartier Al Masiaf de Riyad, y compris la performance énergétique de 3 323 bâtiments urbains, selon huit scénarios différents d’atténuation de la chaleur afin d’évaluer les stratégies optimales pour abaisser la température. de la ville et réduisant les besoins en refroidissement.
La modélisation, qui a pris en compte différentes combinaisons de matériaux super cool, de types de végétation et de niveaux de rénovation énergétique, a révélé qu’il était possible de diminuer la température extérieure de la ville de près de 8,1°F (4,5°C) en été. La stratégie améliorerait également les économies d’énergie de refroidissement pour la ville jusqu’à 16 pour cent.
Le scénario d’atténuation (ou de refroidissement) de la chaleur recommandé pour Riyad comprend l’utilisation de matériaux super froids mis en œuvre sur le toit des bâtiments et plus que doubler le nombre d’arbres irrigués pour améliorer le refroidissement par transpiration.
Au contraire, une mise en œuvre aveugle de techniques de refroidissement urbain non basées sur une optimisation scientifique détaillée et avancée, comme l’utilisation de verdure non irriguée, peut entraîner une augmentation substantielle de la température de la ville.
« En mettant en œuvre la bonne combinaison de technologies et de techniques avancées d’atténuation de la chaleur, il est possible de diminuer la température ambiante à l’échelle de l’enceinte », explique le professeur Santamouris. « Pour une ville étouffante de la taille de Riyad, réduire considérablement les besoins en refroidissement est également formidable pour la durabilité. »
Le professeur Santamouris affirme que l’abaissement de la température de la ville contribue à accroître le confort thermique des habitants, à réduire les problèmes de santé liés à la chaleur intense, à diminuer la concentration de polluants et à améliorer la productivité humaine. Bien qu’elles ne fassent pas partie de cette étude, des recherches antérieures ont révélé que la mise en œuvre de stratégies de refroidissement similaires dans d’autres villes peut contribuer à réduire les décès liés à la chaleur.
Réduire la demande énergétique à l’échelle urbaine
La recherche a également simulé l’impact énergétique des mesures de rénovation pour l’ensemble des 3 323 bâtiments, ainsi que les technologies d’atténuation de la chaleur mises en œuvre à l’échelle urbaine. La combinaison des technologies de refroidissement optimales avec des options de rénovation énergétique – à savoir l’amélioration de l’enveloppe du bâtiment grâce à de meilleures fenêtres, une meilleure isolation, des toits solaires et froids – pourrait réduire la demande de refroidissement jusqu’à 35 %.
« Cela représente une réduction substantielle des besoins énergétiques de Riyad, ce qui contribuerait à réduire davantage les coûts associés au refroidissement de la ville tout en améliorant la qualité de vie de la population locale », déclare le professeur Santamouris.
Les chercheurs espèrent maintenant travailler avec la Commission royale de Riyad pour commencer à mettre en œuvre le plan sur mesure d’atténuation de la chaleur dans la ville, qui serait le plus grand du genre au monde.
« Une fois mises en œuvre à l’échelle de la ville, ces technologies avancées d’atténuation de la chaleur produiront d’importants résultats en matière de santé, de durabilité et d’économie pour la ville pour les années à venir », déclare le professeur Santamouris.
L’équipe de recherche comprenait également des chercheurs du Université de SydneyLaboratoire national Lawrence Berkeley, Commission royale de la ville de Riyad, Université de Calcutta et Université d’Athènes.